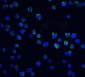
Akirin1 Antibody

More Products ( 4 )
Products labeled with a "crown" meet aggressive quality standards. Learn more.
VIEW MORE
Sort by
| Catalog # | AP17755B |
|---|---|
| Application | WB, E |
| Reactivity | H |
| Accession | Q9H9L7 |
| 400 µl | $ 385.00 | Add to Cart |
| 80 µl | $ 150.00 | Add to Cart |
| Catalog # | AP59134 |
|---|---|
| Application | IHC-P, IHC-F, IF, E |
| Reactivity | Rat, D |
| Accession | Q9H9L7 |
| 100 µl | $ 385.00 | Add to Cart |














 Foundational characteristics of cancer include proliferation, angiogenesis, migration, evasion of apoptosis, and cellular immortality. Find key markers for these cellular processes and antibodies to detect them.
Foundational characteristics of cancer include proliferation, angiogenesis, migration, evasion of apoptosis, and cellular immortality. Find key markers for these cellular processes and antibodies to detect them. The SUMOplot™ Analysis Program predicts and scores sumoylation sites in your protein. SUMOylation is a post-translational modification involved in various cellular processes, such as nuclear-cytosolic transport, transcriptional regulation, apoptosis, protein stability, response to stress, and progression through the cell cycle.
The SUMOplot™ Analysis Program predicts and scores sumoylation sites in your protein. SUMOylation is a post-translational modification involved in various cellular processes, such as nuclear-cytosolic transport, transcriptional regulation, apoptosis, protein stability, response to stress, and progression through the cell cycle. The Autophagy Receptor Motif Plotter predicts and scores autophagy receptor binding sites in your protein. Identifying proteins connected to this pathway is critical to understanding the role of autophagy in physiological as well as pathological processes such as development, differentiation, neurodegenerative diseases, stress, infection, and cancer.
The Autophagy Receptor Motif Plotter predicts and scores autophagy receptor binding sites in your protein. Identifying proteins connected to this pathway is critical to understanding the role of autophagy in physiological as well as pathological processes such as development, differentiation, neurodegenerative diseases, stress, infection, and cancer.
_-_U251_CQ.jpg)